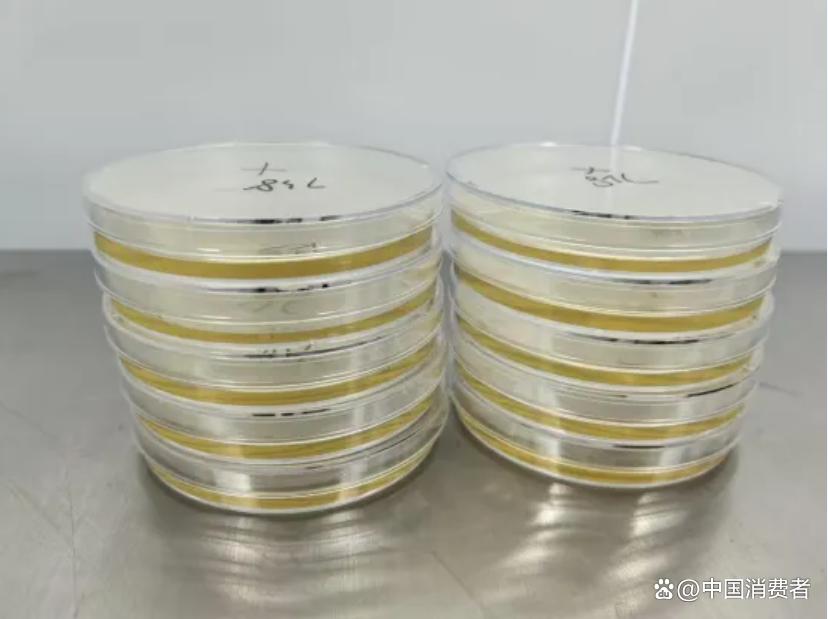
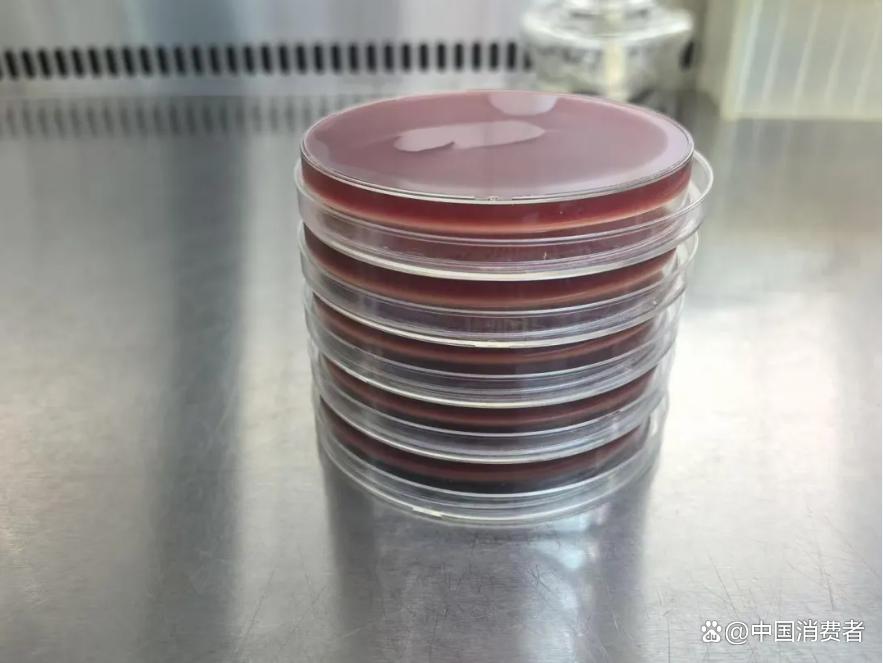

消费者如何看懂卫生巾里的“安全密码”?
中国消费者 2026-03-17 21:33:20
当前中国卫生巾市场呈现稳健增长态势,2025年市场规模达487.3亿元,同比增长8.2%,预计2026年将升至520亿元左右,行业已从数量扩张阶段转向质量提升阶段。消费端呈现明显升级趋势,Z世代成为核心消费群体,高端化、功能化产品需求激增。
尽管行业整体向好,但消费安全焦虑仍是消费者的核心困扰。近年来卫生巾质量丑闻频发,废弃卫生巾翻新销售,部分产品存在荧光剂、甲醛超标,甚至检出有害化学物质,引发消费者广泛担忧。
 5款产品展示
5款产品展示
为纾解消费困惑,帮助消费者科学掌握卫生巾消费知识,近日,中国消费者杂志社从电商平台官方旗舰店购买了5款产品,分别是苏菲超熟睡安心裤、七度空间萌动裤、高洁丝阳光烘烘、护舒宝瞬洁云感、倍舒特甜睡裤,并委托浙江省质量科学研究院国家纺织服装产品质量检验检测中心(浙江),对消费者关注的细菌菌落总数、大肠菌群、金黄色葡萄球菌、可迁移性荧光物质等项目进行了检测。
缘起:卫生巾质量参差不齐引发消费困惑
2025年央视“3·15”晚会曝光的梁山希希纸制品公司翻新卫生巾案例,揭开了卫生巾行业乱象。该公司不仅收购正规厂家残次品,翻新包装后低价售卖,还涉及为多个知名品牌贴牌生产。该违法生产行为彻底颠覆了消费者对卫生巾清洁卫生的认知,也带来了严重的选择困惑。
“3·15”晚会卫生巾曝光事件发生后,卫生巾行业经历严峻的信任危机和自省整改,但产品良莠不齐的市场情形仍然存在。2025年8月,杭州市市场监督管理局发布杭州市流通领域(网络)产品质量监督抽查结果,发现3批次卫生巾不合格。此前,上海市消费者权益保护委员会测评55款卫生巾,发现部分产品实际长度与标示偏差超标准,某品牌偏差达-6%。另有品牌宣称抑菌却实测效果不佳,吸水倍率差异悬殊,最优与最差相差5倍多等。卫生巾是女性生理周期的必需品,但在选购时让消费者陷入两难。选低价产品怕买到翻新、残次品,选高价产品又担心溢价虚高,分不清“医护级”“有机棉”等宣传是否可信。
2025年7月1日,旨在更好规范产品发展,守护消费者健康,由国家市场监督管理总局发布修订后的国家标准《一次性使用卫生用品卫生要求》(GB 15979-2024)正式实施,替代《一次性使用卫生用品卫生标准》(GB15979-2002)。新国标增加了对原材料的卫生要求,明确原材料“无毒、无害”,不应使用废弃或使用过的一次性使用卫生用品作为原材料或半成品,不得检出可迁移性荧光增白剂,并调整了微生物污染指标和毒理学安全性要求。新国标的正式实施为卫生巾行业健康发展带来契机。
当前,一方面消费者对卫生巾产品安全需求高涨,另一方面市场仍存在标准落地滞后,部分小厂违规生产、产品宣传模糊,信息不对称严重等现象。基于上述消费现状,本次检测依据国家标准《一次性使用卫生用品卫生标准》(GB 15979-2024)、《卫生巾(护垫)》(GB/T 8939-2018),对微生物项目中菌落总数、大肠菌群、金黄色葡萄球菌、可迁移性荧光物质4项目进行了检测。
结果:苏菲等5款样品4项目检测均合格
检测结果显示,苏菲超熟睡安心裤、七度空间萌动裤、高洁丝阳光烘烘、护舒宝瞬洁云感、倍舒特甜睡裤等送检样品菌落总数实测值均<5CFU/g,远低于标准≤200CFU/g要求;大肠菌群、金黄色葡萄球菌均未检出;可迁移性荧光物质均未检出。
1.菌落总数
细菌菌落总数是指在一定条件下每克检样所生长出来的细菌菌落总数,是反映一次性使用卫生用品的卫生状况的重要指标,用以判定样品是否被污染,从而评价样品的卫生质量。
按照标准要求,卫生巾微生物学指标中细菌菌落总数要求:消毒级为≤20 CFU/g,普通级为≤200CFU/g。
样品菌落总数检测处理:均质、稀释
样品菌落总数检测处理:均质、稀释
本次检测在5级净化条件下无菌称取样品制成生理盐水样液,取上清液做适宜10倍梯度稀释,选对应稀释度每样2个平皿各加2.0mL样液,倾注40℃~45℃营养琼脂培养基混匀,凝固后倒置于36℃培养箱培养48h,弃去片状生长平皿后计数,按公式计算菌落总数并按数值范围规范报告,首次检测超标需用留样复测 2 次,依复测结果判定合格与否。
检测结果显示,上述苏菲等5款样品菌落总数为<5CFU/g。按检测报告编制要求,只有当2块营养琼脂培养基平皿上的细菌菌落总数为0CFU时,应当报告菌落总数<5CFU/g。
2.大肠菌群、金黄色葡萄球菌等部分特定微生物
大肠菌群是指在一定培养条件下的革兰氏阴性无芽孢杆菌,是反映一次性使用卫生用品受粪便污染程度的卫生指标,用以判定样品是否存在肠道致病菌污染风险,进而评价样品的卫生安全性。
按照微生物学指标中大肠菌群要求,消毒级、普通级卫生巾产品均为不得检出。
本次检测在5级净化条件下无菌称取样品制成生理盐水样液,取上清液接种至乳糖胆盐发酵培养基进行初发酵培养,观察产酸产气情况,对疑似阳性管接种伊红美蓝琼脂平板分离培养,挑取典型菌落进行生化鉴定,综合发酵与鉴定结果判定是否检出。
本次检测按标准方法对样品进行培养后,未观察到符合大肠菌群典型特征的菌落及生化反应结果时,报告大肠菌群未检出。
金黄色葡萄球菌是一种革兰氏阳性球菌,为常见的食源性致病菌,是反映一次性使用卫生用品受致病性微生物污染的重要指标,用以判定样品是否存在金黄色葡萄球菌污染,从而评价样品的卫生安全风险。
按照卫生巾微生物学指标中金黄色葡萄球菌要求,消毒级、普通级卫生巾产品均为不得检出。
 样品大肠菌群的增菌培养
样品大肠菌群的增菌培养
 样品金黄色葡萄球菌的增菌培养
样品金黄色葡萄球菌的增菌培养
金黄色葡萄球菌增菌后的分离培养
金黄色葡萄球菌增菌后的分离培养
本次检测在5级净化条件下无菌称取样品制成生理盐水样液,取上清液接种SCDLP培养液中进行增菌培养,再转接至Baird Parker培养基或血琼脂平板分离培养,挑取疑似菌落进行革兰氏染色、血浆凝固酶试验等鉴定,综合培养与鉴定结果判定是否检出。
本次检测,未观察到符合金黄色葡萄球菌典型特征的菌落及生化、血清学反应结果时,报告金黄色葡萄球菌未检出。苏菲等上述5款样品均未检出。
3.卫生巾可迁移性荧光物质
可迁移性荧光物质指在一定条件下能够从卫生巾产品中转移到人体皮肤或黏膜上的荧光性化学物质。卫生巾中存在荧光剂(荧光增白剂)可能引起皮肤刺激、过敏反应,并存在潜在的致癌风险和内分泌干扰风险,一直以来备受消费者关注。《卫生巾(护垫)》(GB/T 8939-2018)对卫生巾中可迁移性荧光物质的限量有明确规定,要求在特定检测条件下不得检出或符合安全阈值。

本次检测通过将试样与荧光标准样一同置于紫外灯下约20cm处,观察试样两面的荧光并于荧光标准样进行比对。结果显示,5款样品均未检出可迁移性荧光物质。
综合本次检测结果来看,行业头部的几个品牌的产品在安全底线上均表现扎实,尤其是菌落总数实测值远优于国家标准要求,5款送检样品均交出了“全项合格”的成绩单。
消费提示:读懂卫生巾里的安全密码
面对市场上琳琅满目的卫生巾产品,消费者如何科学选购并正确使用,建议掌握下面四个小技巧。
一是选渠道。选购时从正规商超、电商平台以及品牌官方旗舰店购买,避免买到假货;优先选择自有工厂生产的产品,产品质量管控更严。

二是看标识。仔细查看产品包装上的生产日期、保质期、执行标准号及卫生许可证号等信息,卫生巾产品优选标注GB 15979和GB/T 8939国家标准的产品,安心裤产品优选标注GB 15979国家标准的产品,确保产品符合最新安全规范。
三是重体验。首次使用某品牌时建议先购买小包装试用,观察使用过程中是否出现皮肤瘙痒、红肿等不适反应。若发现卫生巾有异味、异常变色或使用后身体不适,应立即停用并保留相关证据通过“全国消协智慧315”平台向消协组织投诉,也可直接向经营者所在地的有关行政部门投诉举报。
四是善储存。卫生巾应存放于干燥清洁处,避免与化妆品、清洁剂等化学品混放,开封后尽快使用完毕,防止受潮滋生细菌。夏季高温或潮湿环境下,更需注意产品保质期,临近过期的产品即使未拆封也建议谨慎使用。
(中国消费者)
责任编辑:房超
